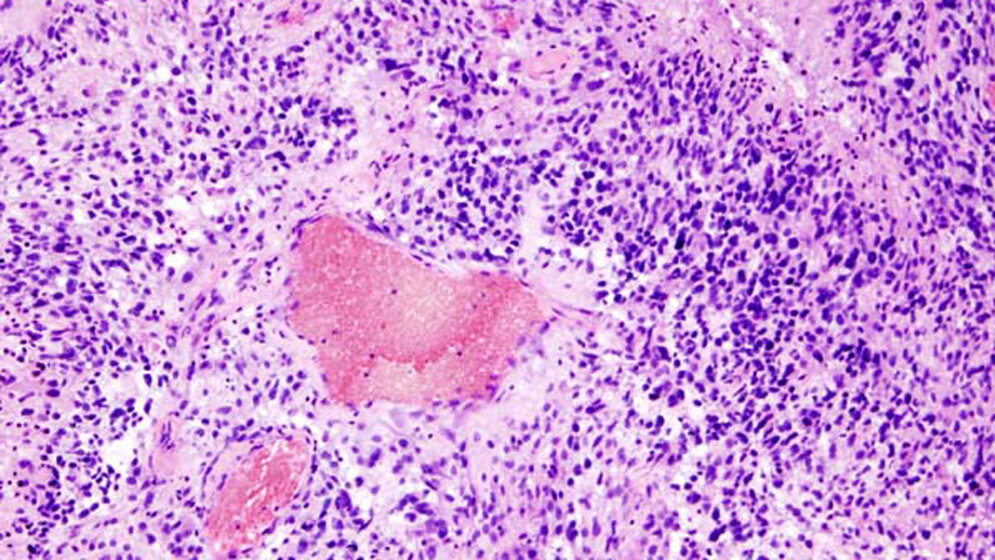
Glioblastom histologisches Präparat

„Sämtliche betroffenen medizinischen Disziplinen in Deutschland arbeiten derzeit an einer gemeinsamen Strategie, um Wissenslücken zu schließen. Dabei gilt es, die möglichen Vorteile der neuen Therapie in die Praxis zu bringen, aber auch, unrealistische Hoffnungen zu vermeiden“, so Professor Wolfgang Wick, der Ärztliche Direktor der Neurologischen Klinik am Universitätsklinikum Heidelberg.
Großangelegte Studie
Annähernd 700 Patienten mit einem neu diagnostizierten Glioblastom hatten an der Studie teilgenommen, deren abschließende Ergebnisse vor Kurzem in der Fachzeitschrift „JAMA“ veröffentlicht wurden. Dabei hatte nach dem Losprinzip ein Drittel der Patienten die Standardtherapie bekommen, bei der die Tumoren zuerst operativ entfernt und verbleibende Krebszellen mit einer kombinierten Strahlen- und Chemotherapie bekämpft werden. Zwei Drittel bekamen zusätzlich die Tumorhauben, die mindestens 18 Stunden am Tag getragen werden müssen.
Überlebenszeit um fünf Monate verlängert
Die Hauben erzeugen elektrische Wechselfelder, die sogenannten Tumortherapiefelder (TTF), welche durch die Schädeldecke abgegeben werden mit dem Ziel, die Teilung von Krebszellen zu verhindern. Patienten, die eine solche Haube trugen, überlebten im Durchschnitt 20,9 Monate gegenüber 16 Monaten für Patienten unter der Standardbehandlung. Betrachtet man die Zeit, in der die Krankheit vorübergehend zum Stillstand gebracht wurde (progressionsfreies Überleben), so waren es mit TTF 6,7 Monate und ohne 4,0 Monate (nach Abschluss der Strahlen- und konkomitanten Chemotherapie). Als zusätzliche Nebenwirkungen gab es unter den TTF Hautreizungen bei etwa der Hälfte der Patienten. Nicht gemessen wurde jedoch eine mögliche psychische Belastung, die dadurch entstehen könnte, dass die Patienten die mit einem Kabelstrang versorgte Haube dauerhaft auf dem Kopf tragen müssen.
Sinnvolle Behandlungsergänzung?
„Wir sehen in den TTF Potenzial; möglicherweise sind sie eine sinnvolle Behandlungsergänzung“, sagt Professor Uwe Schlegel (Bochum), einer der federführenden Autoren für die Leitlinie „Hirntumoren“ der DGN und Mitglied im Beirat der Neuroonkologischen Arbeitsgemeinschaft in der Deutschen Krebsgesellschaft. „Für eine abschließende Bewertung ist jedoch eine vom Hersteller der Geräte unabhängige Studie wichtig“, so Schlegel. Für die Systeme wird nämlich ein intensives Marketing betrieben. Anträge auf Erstattung der Kosten von monatlich etwa 23.000 Euro pro Patient werden von den Krankenkassen in Deutschland meistens bewilligt.
Echte Kontrollgruppe fehlte
Dabei sind die Patienten wie auch in der aktuellen Studie in häufigem Kontakt mit medizinisch-technischen Firmenvertretern. „Es ist nicht auszuschließen, dass dies zusätzliche Unterstützung gegeben haben könnte, denn es gab weder in früheren Untersuchungen noch in der aktuellen Studie eine echte Kontrollgruppe“, so Wick.
Patienten verlangen die Hauben
Natürlich hat sich die Nachricht von dem möglicherweise lebensverlängernden Effekt unter Glioblastom-Patienten herumgesprochen. In manchen Tumorzentren werden die „Wechselstromhauben“ nur von einigen wenigen Personen pro Jahr verlangt, in anderen sind es bis zu 20 Prozent der Patienten. Eine Empfehlung zur Durchführung der Therapie in den nationalen oder Europäischen Leitlinien existiert aber nicht, sie ist in den Europäischen wie auch US-amerikanischen Leitlinien lediglich als eine Option erwähnt.
Hohe Kosten, intensives Marketing
„Vor diesem Hintergrund verwundert das intensive Marketing der Firma Novocure ebenso wie der Wunsch, eine kommerzielle Anwendungsbeobachtungsstudie durchzuführen. Die im Sommer letzten Jahres publizierten Protokolle aus den Diskussionen beim für die Kostenerstattung zuständigen Gemeinsamen Bundesausschuss (G-BA) legen nahe, dass für Deutschland eine weitere kontrollierte Studie durchgeführt werden soll, bevor über eine allgemeine Kostenerstattung gesprochen werden kann“, so Wick. „Stattdessen erfahren wir von Patienten, dass ihnen zugeraten wird, die Hauben auch dann noch zu tragen, wenn die Krankheit wieder fortschreitet, obwohl ein Nutzen in dieser Phase nicht nachgewiesen ist.“
Ein Strohhalm für schwer kranke Patienten
„Viele Kollegen sehen die TTF kritisch, haben Zweifel an der Auswahl der Patienten in der aktuellen Studie und halten es für möglich, dass nicht die Methode selbst, sondern die zusätzliche Betreuung in der Studie die Unterschiede in der Überlebensdauer erklären könnte“, sagt Schlegel. Auch viele Patienten sind zurückhaltend, wenn ihnen klar wird, dass die Tumorfeldtherapie auch nur einen in wenigen Monaten zu bemessenden Aufschub der Erkrankung bedeutet und nicht etwa Heilung. „Einmal begonnen, stellt die Tumorfeldtherapie bei der lebensbedrohlichen Erkrankung einen Strohhalm dar“, so Wick.
Keine eindeutige Empfehlung
Neurologen und Krebsärzte bieten in dieser Situation eine ausführliche und offene Beratung an, und sie akzeptieren und unterstützen die Entscheidung der Patienten. „Eine eindeutige Empfehlung können wir jedoch nicht abgeben, bevor die positiven Resultate aus der aktuellen, vom Hersteller finanzierten Untersuchung von einer weiteren, unabhängigen Arbeitsgruppe im Vergleich zu einer Placebo-Behandlung bestätigt werden“, so Wick weiter. (idw, red)
Stupp R et al.: Effect of Tumor-Treating Fields Plus Maintenance Temozolomide vs Maintenance Temozolomide Alone on Survival in Patients With Glioblastoma: A Randomized Clinical Trial. JAMA. 2017 Dec 19; 318 (23): 2306–2316, DOI: 10.1001/jama.2017.18718.
Artikel teilen